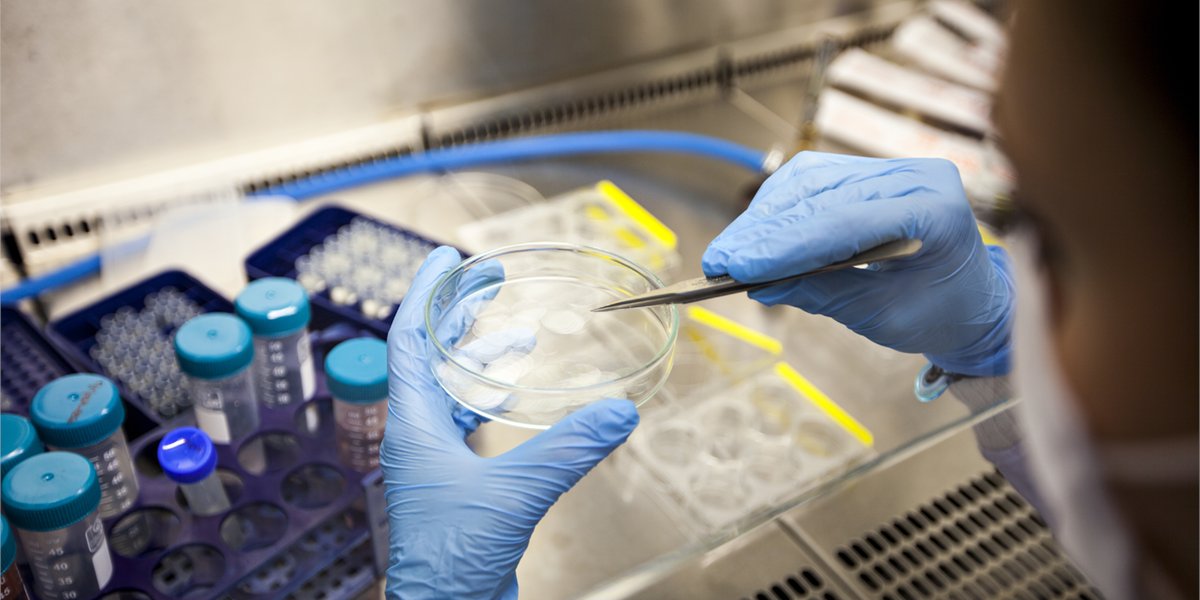
WimsigAU's tweet card. Nine University of Sydney researchers have secured over $10 million in Australian Research Council (ARC) Future Fellowships.

SydMathInst
@SydMathInst
Sydney Mathematical Research Institute (SMRI) Transforming maths in Australia w/ research and public outreach. [email protected] YouTube http://bit.ly/SMRI_YT
We are delighted to announce that Zsuzsanna Dancso @ZsuzsiDancso will give our next #PublicLecture: 'Knots, graphs, and algebra: a story of surprises' will be on Friday 15 August, as part of our program for #NationalScienceWeek 🪢More information and registration:…

Two years ago, I had an epiphany, which led me to pivot my research towards mathematics for quantum era security. We’re nowhere near where I’d like to be yet, but I hope that these tantalizing new ideas will lead us to an incredible new perspective …
The quantum revolution promises breakthroughs in medicine, energy and materials, but also threatens the encryptions that protect our digital lives. Prof Nalini Joshi AO is building quantum-resilient algorithms to keep us secure. Learn more about her work: go.sydney.edu.au/P6BvgL




The quantum revolution promises breakthroughs in medicine, energy and materials, but also threatens the encryptions that protect our digital lives. Prof Nalini Joshi AO is building quantum-resilient algorithms to keep us secure. Learn more about her work: go.sydney.edu.au/P6BvgL




Calling algebraic geometers 📣 do you have any images of examples of bielliptic surfaces?
Join us next Monday for a talk by Dr Yimin Zheng from @CeMM_News! 🌟 🔬The lazy way of pathological images analysis in the era of large models ⏱️ 18 August, 1 pm (AEST) 🔗 bit.ly/4hZLxiR

Celebrate #ScienceWeek2025 with family-friendly science activities, talks & panels hosted by @SydMathInst, @Sydney_Science & @ccwm_sydney ⚛️ Find out more: go.sydney.edu.au/i2vDkq

Knots are everywhere: DNA, materials, and maths. How can we use algebra to unravel their mysteries? Join this public lecture hosted by @SydMathInst, as part of National Science Week. Register now: srkr.io/6015guc

Science at the Museum is happening at the Chau Chak Wing Museum on Saturday 16th and Sunday 17th August! Join us as we team up again with the museum for a program loaded with activities for the whole family! #ScienceWeek …ical-research-institute.sydney.edu.au/event/science-…

Join 'Zsuzsanna Dancso' for a mind-bending #NationalScienceWeek public lecture exploring the unexpected beauty of mathematics. Title: 'Knots, graphs, and algebra: a story of surprises' 🎟️ Free registration: events.humanitix.com/knots-graphs-a… #Maths #SciWeek #PublicLecture #USyd
events.humanitix.com
'Knots, graphs, and algebra: a story of surprises' by Zsuzsanna Dancso - National Science Week...
Zsuzsanna Dancso: Knots, graphs, and algebra: a story of surprises - a public lecture by Sydney Mathematical Research Institute
Just one more week left to apply for the International Visitor Program at SMRI! Please share this incredible opportunity with your #Mathematics networks Full T+Cs and application: …ical-research-institute.sydney.edu.au/international-… #Math #Research
Our visitor program affords maths researchers time & space to think in a collaborative environment. Spend time with Aus-based mathematicians in the quadrangle at @Sydney_Uni - applications for 2026+ visits close August 1! 🗓️🐨🧮 #MathSky T+Cs: …ical-research-institute.sydney.edu.au/international-…
👏 Dr Anne Thomas has been awarded a prestigious ARC Future Fellowship, recognizing her outstanding research and commitment to advancing knowledge in areas of national and global importance. Read more: sydney.edu.au/news-opinion/n… #ARC #FutureFellowships #STEM
Our visitor program affords maths researchers time & space to think in a collaborative environment. Spend time with Aus-based mathematicians in the quadrangle at @Sydney_Uni - applications for 2026+ visits close August 1! 🗓️🐨🧮 #MathSky T+Cs: …ical-research-institute.sydney.edu.au/international-…
📢 HDR scholarships available @Sydney_Uni in Mathematics for Quantum Resources! Open to Australian citizens, PRs, & NZ citizens. Keen to support applicants from underrepresented groups. 🔗 Apply now: sydney.edu.au/scholarships/d…
🎉 Congratulations to Prof Nalini Joshi on being awarded Honorary Member of the London Mathematical Society - a prestigious recognition of her outstanding contributions to mathematics! 👏 🔗 More info: lms.ac.uk/news/lms-honor… #WomenInSTEM #Mathematics #LMS #AcademicExcellence
Sharing 3 x scholarship opportunities with @monsoon0: Postgrad Research in Mathematics for Quantum Resilience Quantum computing will be revolutionary- Qs about online security & unexpected discoveries remain. Please share with your networks - details about eligibility and how to…

🧮 View the #AMSISummerSchool 2026 subject list! Choose from 9 honours/masters level subjects. Expand your mathematical world at our 24th summer school hosted by @MonashUni from 12 Jan - 6 Feb 2025 📚 Subject guides now available @AustMS #ANZAMP @StatSocAus
Applications are now open for our International Visitors Program, open to #mathematicians to visit Australia 🐨 between July '26- 'June 27, or March '26-June -27 (Aus/NZ citizens) 📅 Apply by August 1, more info: …ical-research-institute.sydney.edu.au/international-… Please RT and share 🔁
✨️Don't miss this amazing talk!! "Great conversations all the time in a unique inspire place" what a great definition of @SydMathInst ✨️ #inspirecreativity youtu.be/NZuHYGCF3-A?si…

youtube.com
YouTube
In conversation: Masoud Kamgarpour chats to Charlotte Chan and Thomas...
I will be advertising 3 postgraduate research scholarships in #mathematics for #quantum resilience soon. Let me know if you’re interested, but note that applicants will need to be an Australia citizen, permanent resident or New Zealand citizen.
Today is #May12, a worldwide celebration of women in mathematics, marking the birthday of Maryam Mirzakhani, who passed away at the age of 40. Dozens of events are taking place all across the world ➡️ may12.womeninmaths.org #WomenInMaths #May12 #May12WIM

United States الاتجاهات
- 1. Mamdani 283K posts
- 2. Kandi 4,738 posts
- 3. Mama Joyce 1,294 posts
- 4. #ItsGoodToBeRight N/A
- 5. #HMGxBO7Sweeps 1,494 posts
- 6. Egg Bowl 2,191 posts
- 7. Brandon Aiyuk N/A
- 8. Chance Moore N/A
- 9. #BY9sweepstakes N/A
- 10. Ukraine 598K posts
- 11. Adolis Garcia 1,954 posts
- 12. #AleMeRepresenta N/A
- 13. Putin 209K posts
- 14. Richie Saunders N/A
- 15. Wisconsin 8,411 posts
- 16. Joshua 40.9K posts
- 17. El Bombi N/A
- 18. #DanSeats N/A
- 19. Nolan Jones N/A
- 20. Kiffin 11K posts
Something went wrong.
Something went wrong.